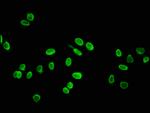
Hydroxyl-Histone H4 (Tyr88) Antibody in Immunocytochemistry (ICC/IF)

Search
Invitrogen
Hydroxyl-Histone H4 (Tyr88) Polyclonal Antibody
{{$productOrderCtrl.translations['antibody.pdp.commerceCard.promotion.promotions']}}
{{$productOrderCtrl.translations['antibody.pdp.commerceCard.promotion.viewpromo']}}
{{$productOrderCtrl.translations['antibody.pdp.commerceCard.promotion.promocode']}}: {{promo.promoCode}} {{promo.promoTitle}} {{promo.promoDescription}}. {{$productOrderCtrl.translations['antibody.pdp.commerceCard.promotion.learnmore']}}
图: 1 / 2
Hydroxyl-Histone H4 (Tyr88) Antibody (PA5-112568) in ICC/IF

Please note: We are reviewing Western blot images included in the antibody testing data in our catalog, including those provided by third parties. Unless expressly labeled or annotated as “raw-unedited”, Western blot images included in the antibody testing data in our catalog may have been edited, optimized or otherwise adjusted for presentation.
产品信息
PA5-112568
种属反应
宿主/亚型
分类
类型
抗原
偶联物
形式
浓度
规格
纯化类型
保存液
内含物
保存条件
运输条件
RRID
靶标信息
Histones are basic nuclear proteins that are responsible for the nucleosome structure of the chromosomal fiber in eukaryotes. Two molecules of each of the four core histones (H2A, H2B, H3, and H4) form an octamer, around which approximately 146 bp of DNA is wrapped in repeating units, called nucleosomes. The linker histone, H1, interacts with linker DNA between nucleosomes and functions in the compaction of chromatin into higher order structures. This gene is intronless and encodes a member of the histone H4 family. Transcripts from this gene lack polyA tails but instead contain a palindromic termination element. This gene is found in the large histone gene cluster on chromosome 6.
仅用于科研。不用于诊断过程。未经明确授权不得转售。
篇参考文献 (0)
生物信息学
蛋白别名: Histone 4; Histone Cluster 4; Histone H4; Histone H4A
基因别名: H4-16; H4/A; H4/B; H4/C; H4/D; H4/E; H4/G; H4/H; H4/I; H4/J; H4/K; H4/M; H4/N; H4/O; H4C1; H4C11; H4C12; H4C13; H4C14; H4C15; H4C16; H4C2; H4C3; H4C4; H4C5; H4C6; H4C8; H4C9; H4F2; H4FA; H4FB; H4FC; H4FD; H4FE; H4FG; H4FH; H4FI; H4FJ; H4FK; H4FM; H4FN; H4FO; HIST1H4A; HIST1H4B; HIST1H4C; HIST1H4D; HIST1H4E; HIST1H4F; HIST1H4H; HIST1H4I; HIST1H4J; HIST1H4K; HIST1H4L; HIST2H4; HIST2H4A; HIST2H4B; HIST4H4
Entrez Gene ID: (Human) 8359, (Human) 8363, (Human) 8370, (Human) 121504, (Human) 8366, (Human) 8367, (Human) 8294




